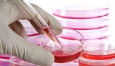
������ ������ ����� ����� ���������������� � ���������

-
Разработана умная одежда для грудных детей
 Смарт одежда для грудничков призвана защитить детей от внешних факторов сразу после рождения
Смарт одежда для грудничков призвана защитить детей от внешних факторов сразу после рождения
24.04.2014 20:15 МедСтенд
-
Приложения для отслеживания развития плода при ЭКО
 Великие умы современности, с помощью компьютеров и гаджетов создают плацдарм для новых методов лечения и диагностики
Великие умы современности, с помощью компьютеров и гаджетов создают плацдарм для новых методов лечения и диагностики
21.03.2014 21:36 МедСтенд
-
3D технологии – спасают жизнь
 На 3D принтере напечатали эластичную мембрану, которая своим строением напоминает внешний слой сердечной стенки
На 3D принтере напечатали эластичную мембрану, которая своим строением напоминает внешний слой сердечной стенки
27.02.2014 16:08 МедСтенд
-
Бессонница равносильна сотрясению мозга - ученые
 Во время бодрствования и длительной бессонницы в организме человека накапливаются вещества обнаруживаемые при травмах головного мозга
Во время бодрствования и длительной бессонницы в организме человека накапливаются вещества обнаруживаемые при травмах головного мозга
26.02.2014 14:36 МедСтенд
-
Китайцы научились предсказывать дату смерти человека
 Используя митохондриальный генез китайские исследователи установили зависимость окислительной способности митохондрий от старения организма человека
Используя митохондриальный генез китайские исследователи установили зависимость окислительной способности митохондрий от старения организма человека
19.02.2014 12:08 МедСтенд
-
Невероятно: чтобы лучше видеть, надо больше двигаться
 Американские исследователи доказали положительное влияние физических нагрузок на зрение
Американские исследователи доказали положительное влияние физических нагрузок на зрение
17.02.2014 13:14 МедСтенд
-
Связь между протянутыми над домами ЛЭП и детской лейкемией опровергнута
 Британские учёные изучили статистику новых случаев заболевания раком крови - лейкемией у детей живущих в непосредственной близости к линиям электропередач
Британские учёные изучили статистику новых случаев заболевания раком крови - лейкемией у детей живущих в непосредственной близости к линиям электропередач
11.02.2014 10:46 МедСтенд
-
Высокие технологии: Новый способ исследования кишечника
 В эпоху всевозможных гаджетов, наиболее полезным для здоровья стала возможность получать снимки высокого разрешения в миниатюрных приборах
В эпоху всевозможных гаджетов, наиболее полезным для здоровья стала возможность получать снимки высокого разрешения в миниатюрных приборах
07.02.2014 08:38 МедСтенд
-
Сенсационные исследования о ВПЧ человека
 Папилломой организм человека заражает себя сам, такие неожиданные данные получили в США во время исследований ВПЧ во Флориде
Папилломой организм человека заражает себя сам, такие неожиданные данные получили в США во время исследований ВПЧ во Флориде
05.02.2014 13:00 МедСтенд
-
Старые клетки крови можно трансформировать в стволовые
Ученые решили этическую сторону проблемы получения стволовых клеток. Теперь их можно получать из крови пациента без использования эмбриона
Ученые решили этическую сторону проблемы получения стволовых клеток. Теперь их можно получать из крови пациента без использования эмбриона
02.02.2014 11:15 МедСтенд
-
Съесть арахис и не умереть
 Арахис является наиболее распространенной причиной смертельных аллергических реакций
Арахис является наиболее распространенной причиной смертельных аллергических реакций
31.01.2014 18:50 МедСтенд
-
Российские ученые начали выращивать элементы кожи, пригодные для пересадки
 В екатеринбургском Институте медицинских клеточных технологий открылась лаборатория по выращиванию слоя соединительной ткани - клеток-фибробластов
В екатеринбургском Институте медицинских клеточных технологий открылась лаборатория по выращиванию слоя соединительной ткани - клеток-фибробластов
31.01.2014 12:50 MedDaily
-
Наступать на одни те же грабли заставляет нас вполне определенная часть мозга
 Ученым удалось точно определить область головного мозга, которая позволяет людям совершать одну и ту же глупость дважды
Ученым удалось точно определить область головного мозга, которая позволяет людям совершать одну и ту же глупость дважды
29.01.2014 16:22 МедСтенд.Ru
Реклама
самое популярное сегодня
- 1Подавление моргания показывает, как мозг фильтрует речь в шумной обстановке
- 2Первенцы имеют больше проблем со здоровьем в среднем возрасте
- 3Новый инструмент искусственного интеллекта не только идентифицирует генетические мутации, но и предсказывает тип заболевания
- 4Популярные видеоигры могут принести значимую эмоциональную пользу молодым людям
- 5Наступать на одни те же грабли заставляет нас вполне определенная часть мозга
-
Добавить новость
Опрос

